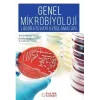
Genel Mikrobiyoloji Laboratuvarı Uygulamaları
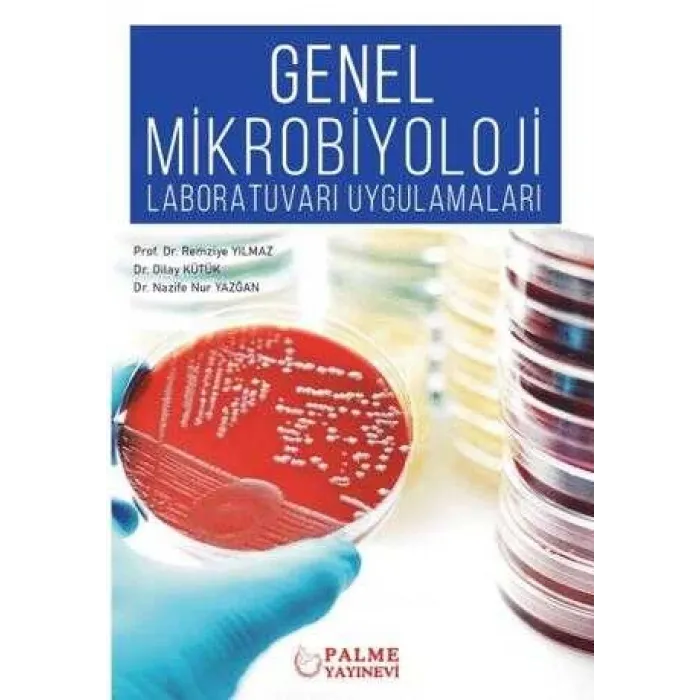
Genel Mikrobiyoloji Laboratuvarı Uygulamaları

Kategoriler
-
Kitap
Akademik Bilgisayar Bilim - Mühendislik Çocuk Kitapları Edebiyat Eğitim Ekonomi Felsefe Genel Konular Gezi ve Rehber Kitapları YKS Kitapları DGS Kitapları ALES Kitapları KPSS Kitapları YDS Kitapları İlkokul Kitapları LGS Kitapları Ortaokul Kitapları Lise Kitapları Mülakat Kitapları Uygun Kitap Al Uygun Kitap Al İslam Kitapları
- Kırtasiye Ofis Malzemeleri
- Tümünü Gör